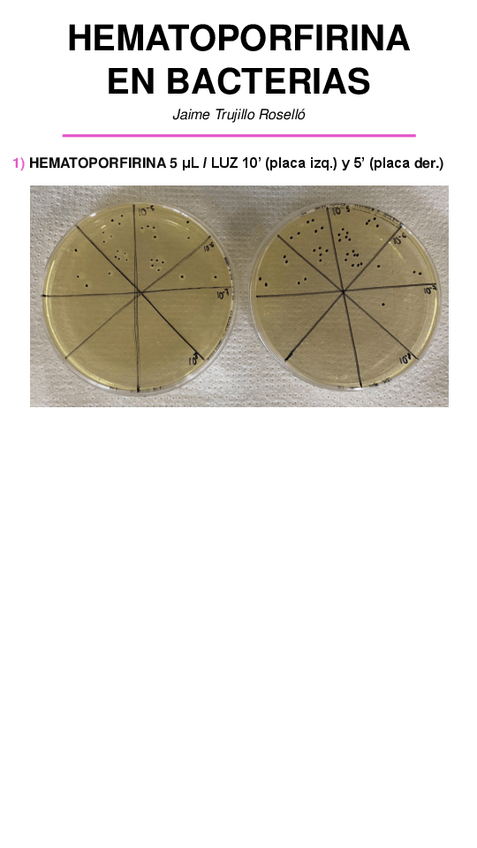

@jaimet01
211 Publicaciones
8.95k Interacciones
2 Seguidores
0 Siguiendo
Lista de publicaciones de jaimet01
trabajos
-
Seminario y Póster
He publicado nuevos trabajos de 4º Fotobioquimica y Fotobiologia: Seminario y Póster
practicas
-
Resultados PL3
He publicado nuevos practicas de 4º Fotobioquimica y Fotobiologia: Resultados PL3
He publicado nuevos practicas de 4º Fotobioquimica y Fotobiologia: Resultados-PL2.xlsx
practicas
-
Resultados PL1
He publicado nuevos practicas de 4º Fotobioquimica y Fotobiologia: Resultados PL1
apuntes
-
Preguntas de desarrollo
He publicado nuevos apuntes de 4º Fotobioquimica y Fotobiologia: Preguntas de desarrollo
ejercicios
-
Supuestos prácticos resueltos
He publicado nuevos ejercicios de 4º Bioquímica y Sociedad: Supuestos prácticos resueltos
practicas
-
Tareas resueltas
He publicado nuevos practicas de 4º Bioquímica y Sociedad: Tareas resueltas
apuntes
-
Preguntas resueltas
He publicado nuevos apuntes de 4º Virología: Preguntas resueltas
trabajos
-
Seminario Arenavirus
He publicado nuevos trabajos de 4º Virología: Seminario Arenavirus
trabajos
-
Seminario
He publicado nuevos trabajos de 4º Química Bioorgánica: Seminario